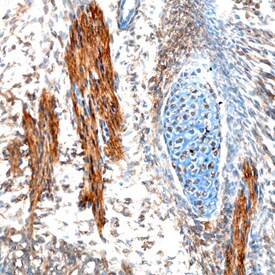
EBF2 Antibody in Immunohistochemistry (Frozen) (IHC (F))

Search
Invitrogen
EBF2 Polyclonal Antibody
{{$productOrderCtrl.translations['antibody.pdp.commerceCard.promotion.promotions']}}
{{$productOrderCtrl.translations['antibody.pdp.commerceCard.promotion.viewpromo']}}
{{$productOrderCtrl.translations['antibody.pdp.commerceCard.promotion.promocode']}}: {{promo.promoCode}} {{promo.promoTitle}} {{promo.promoDescription}}. {{$productOrderCtrl.translations['antibody.pdp.commerceCard.promotion.learnmore']}}
图: 1 / 3
EBF2 Antibody (PA5-47890) in IHC (F)



产品信息
PA5-47890
种属反应
已发表种属
宿主/亚型
分类
类型
抗原
偶联物
形式
浓度
规格
纯化类型
保存液
内含物
保存条件
运输条件
RRID
产品详细信息
In direct ELISAs, less than 1% cross-reactivity with recombinant mouse (rm) EBF-1 and rmEBF-3 is observed.
Reconstitute in sterile PBS to a final concentration of 0.2 mg/mL.
靶标信息
Early B-cell factor 2 (EBF2) is a gene located on chromosome 8p11.23, encoding a transcription factor involved in the regulation of gene expression during neural and adipose tissue development. EBF2 belongs to the COE family of transcription factors and plays a pivotal role in cellular differentiation processes. In the nervous system, EBF2 is essential for the development and function of neurons, particularly in regions like the olfactory system. Additionally, EBF2 is involved in adipogenesis, where it regulates genes responsible for the differentiation of brown adipocytes, contributing to thermogenesis and energy metabolism. Dysfunction or altered expression of EBF2 can impact neurological function and metabolic homeostasis, potentially influencing conditions such as obesity, diabetes, and neurodevelopmental disorders. Research into EBF2 is exploring its role in these physiological contexts and the implications of its regulatory mechanisms, offering insights into potential therapeutic approaches.
仅用于科研。不用于诊断过程。未经明确授权不得转售。
生物信息学
蛋白别名: Collier, Olf and EBF 2; Collier, Olf and EBF transcription factor 2; early B cell factor 2; Early B-cell factor 2; EBF-2; MET-mesencephalon-olfactory TF1; MET-mesencephalon-olfactory transcription factor 1; metencephalon-mesencephalnon-olfactory transcription factor 1; Metencephalon-mesencephalon-olfactory transcription factor 1; O/E-3; OLF-1/EBF-LIKE 3; Transcription factor COE2; unnamed protein product
基因别名: COE2; D14Ggc1e; EBF-2; EBF2; Mmot1; O/E-3; OE-3
UniProt ID: (Human) Q9HAK2, (Mouse) O08792
Entrez Gene ID: (Human) 64641, (Mouse) 13592